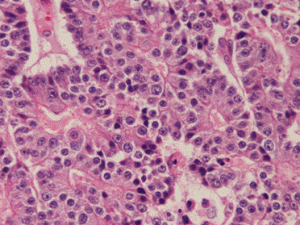

膵EUS‐FNAで採取された腺房細胞癌の一例
症例
膵EUS-FNA 60歳代 男性
細胞診所見
背景に組織球やライトグリーンに染まる顆粒が認められ、腺房を形成するような形態の細胞集塊が多数出現していた。
細胞質は境界不明瞭で、ライトグリーンに淡染する顆粒が認められた。
核は一部裸核状になり、小型類円形を呈し、クロマチンは細顆粒状で増量していた。
核小体は1個で赤く軽度腫大していた。
細胞質は境界不明瞭で、ライトグリーンに淡染する顆粒が認められた。
核は一部裸核状になり、小型類円形を呈し、クロマチンは細顆粒状で増量していた。
核小体は1個で赤く軽度腫大していた。